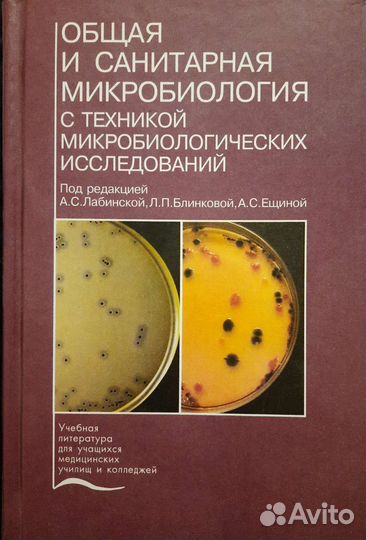
Книга Общая и санитарная микробиология Лабинская

Книга Общая и санитарная микробиология Лабинская
1 800 руб.
Общая и санитарная микробиология под редакцией А.С. Лабинской, Л.П. Бликовой, А.С. Ещиной. Новая, лежала на полке. Оглавление в фото
Объвление найдено на сайте avito.ru. Перейдите по ссылке для покупки или просмотра более подробной информации